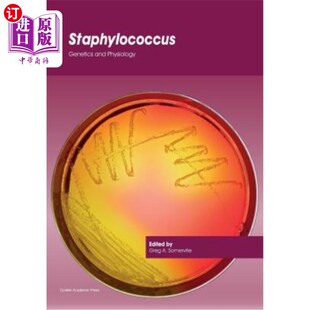
海外直订Staphylococcus: Genetics and Physiology 葡萄球菌:遗传学和生理学

![按需印刷Vancomycin and Staphylococcus Aureus Capsule Gene[9783838383989]](https://img.alicdn.com/bao/uploaded/i2/1899623276/O1CN0188jzqb1a4SIkU0iZz_!!0-item_pic.jpg_310x310.jpg)
按需印刷Vancomycin and Staphylococcus Aureus Capsule Gene[9783838383989]


预订Investigation of the Antibacterial Activity of three types of medicated soaps on Staphylococcus aure


预订"Staphylococcus aureus" contamination levels in selected local herbal medicines sold in Kampala, Uga


【预售】Staphylococcus Aureus Infection and Disease


【预售】Staphylococcus Aureus Infection and Disease


【预订】Staphylococcus Epidermidis: Methods ...


预订 The Efficacy Of Herbal Mixtures On Some Bacteria. Staphylococcus aureus and Streptococcus pyogene: 9783346801661


【预订】Methicillin-Resistant Staphylococcus Aureus (MRSA) Protocols


【预售】Staphylococcus aureus


【预订】Methicillin-Resistant Staphylococcus...


【预订】Methicillin-Resistant Staphylococcus aureus (MRSA) Protocols


【预订】Staphylococcus aureus 9781071615522


预订 Investigation of the Antibacterial Activity of three types of medicated soaps on Staphylococcus aureus: 97836686296


预订 Structural and Functional Characterization of Staphylococcus aureus Enolase: 9783346789334


预订 Staphylococcus: Genetics and Physiology


预订 Staphylococcus aureus: Interplay between Bacteria and Hosts 金黄色葡萄球菌:细菌与宿主之间的相互作用: 9789819994304


【预订】Methicillin-Resistant Staphylococcus Aureus (MRSA) Protocols

![[预订]Staphylococcus aureus Toxins 9783039214259](https://img.alicdn.com/bao/uploaded/i1/454266620/O1CN01sB9nl41ym0s0iHTOP_!!2-item_pic.png_310x310.jpg)
[预订]Staphylococcus aureus Toxins 9783039214259


【预订】Staphylococcus Epidermidis


预订 Staphylococcus aureus


【预售】Methicillin-Resistant Staphylococcus Aureus (Mrsa)


【预售】Methicillin-Resistant Staphylococcus Aureus (M...


海外直订E Coli, Salmonella & Staphylococcus Aureus in Poultry Meat 禽肉中的大肠杆菌、沙门氏菌和金黄色葡萄球菌


【预售】Staphylococcus Aureus: Microbiology, Pathology, Immunology, Therapy and Prophylaxis

![[预订]Staphylococcus Aureus 9781789845921](https://img.alicdn.com/bao/uploaded/i3/454266620/O1CN01N1eNlu1ym0rm68eQV_!!2-item_pic.png_310x310.jpg)
[预订]Staphylococcus Aureus 9781789845921

![[预订]Staphylococcus and Streptococcus 9781789844726](https://img.alicdn.com/bao/uploaded/i4/454266620/O1CN01wmzgVz1ym0pd5txKf_!!2-item_pic.png_310x310.jpg)
[预订]Staphylococcus and Streptococcus 9781789844726


预订 Staphylococcus aureus and antibiotic resistance: What’s new? 金黃色葡萄球菌與抗生素耐藥性:有什麼新進展?: 9786208

![[预订]Insights Into Drug Resistance in Staphylococcus aureus 9781839627422](https://img.alicdn.com/bao/uploaded/i2/454266620/O1CN01EE9hSl1ym0pqJ3g0T_!!2-item_pic.png_310x310.jpg)
[预订]Insights Into Drug Resistance in Staphylococcus aureus 9781839627422

![[预订]Quorum Sensing and Biofilm Formation in Staphylococcus Aureus 9783838138411](https://img.alicdn.com/bao/uploaded/i2/454266620/O1CN01sVIodA1ym0s2Q6KPk_!!2-item_pic.png_310x310.jpg)
[预订]Quorum Sensing and Biofilm Formation in Staphylococcus Aureus 9783838138411


【预售】Staphylococcus aureus

![[预订]Detection of Staphylococcus aureus and Acinetobacter baumannii 9783330843608](https://img.alicdn.com/bao/uploaded/i2/454266620/O1CN01VxJkxp1ym0rqj5iri_!!2-item_pic.png_310x310.jpg)
[预订]Detection of Staphylococcus aureus and Acinetobacter baumannii 9783330843608


【预售】Staphylococcus: Molecular Genetics


海外直订医药图书Staphylococcus Epidermidis: Methods and Protocols 表皮葡萄球菌:方法和方案


海外直订医药图书Staphylococcus Epidermidis: Methods and Protocols 表皮葡萄球菌:方法和方案


海外直订Methicillin-Resistant Staphylococcus Aureus (Mrsa) Protocols 耐甲氧西林金黄色葡萄球菌(Mrsa)方案


Staphylococcus aureus Toxins 金黄色葡萄球菌毒素【中商原版】


海外直订医药图书Staphylococcus Aureus Infection and Disease 金黄色葡萄球菌感染与疾病


海外直订医药图书Staphylococcus Aureus Infection and Disease 金黄色葡萄球菌感染与疾病


海外直订Staphylococcus: Molecular Genetics 葡萄球菌:分子遗传学

海外直订Staphylococcus: Genetics and Physiology 葡萄球菌:遗传学和生理学

